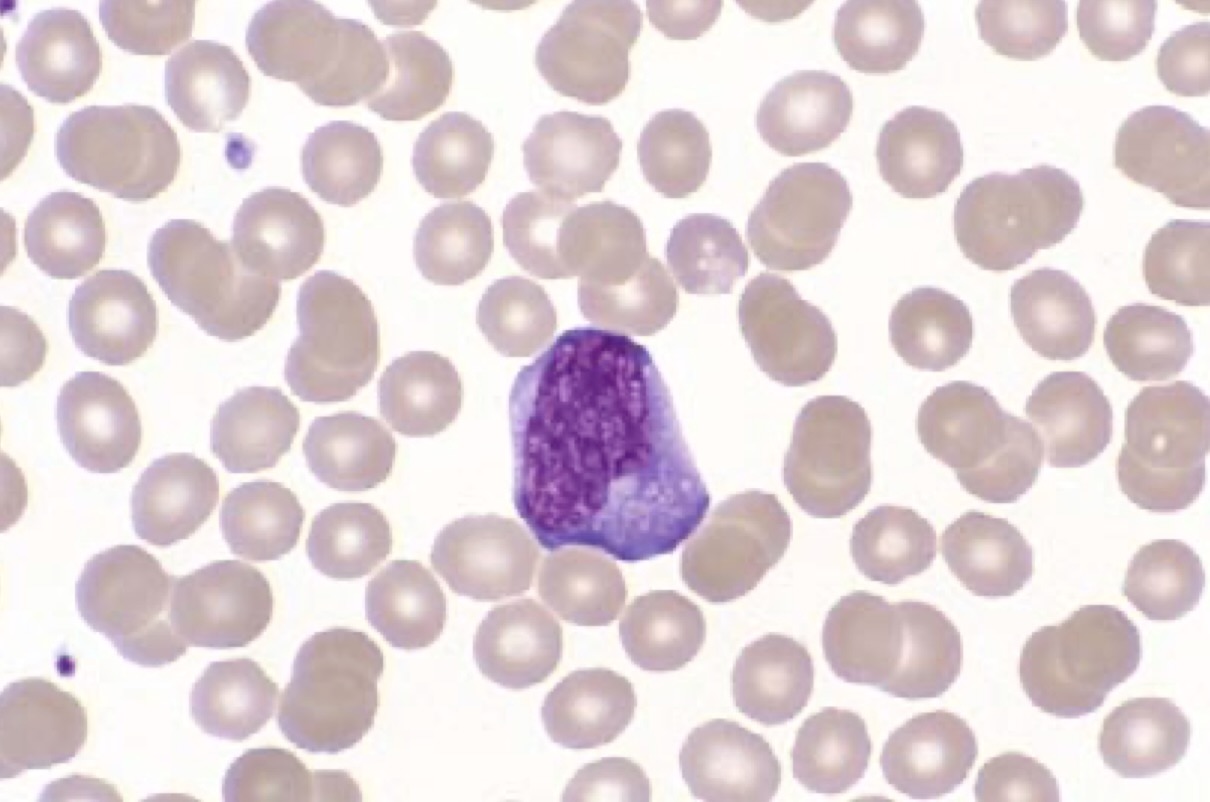
لنفوسیت ری اکتیو در مونونوکلئوز عفونی
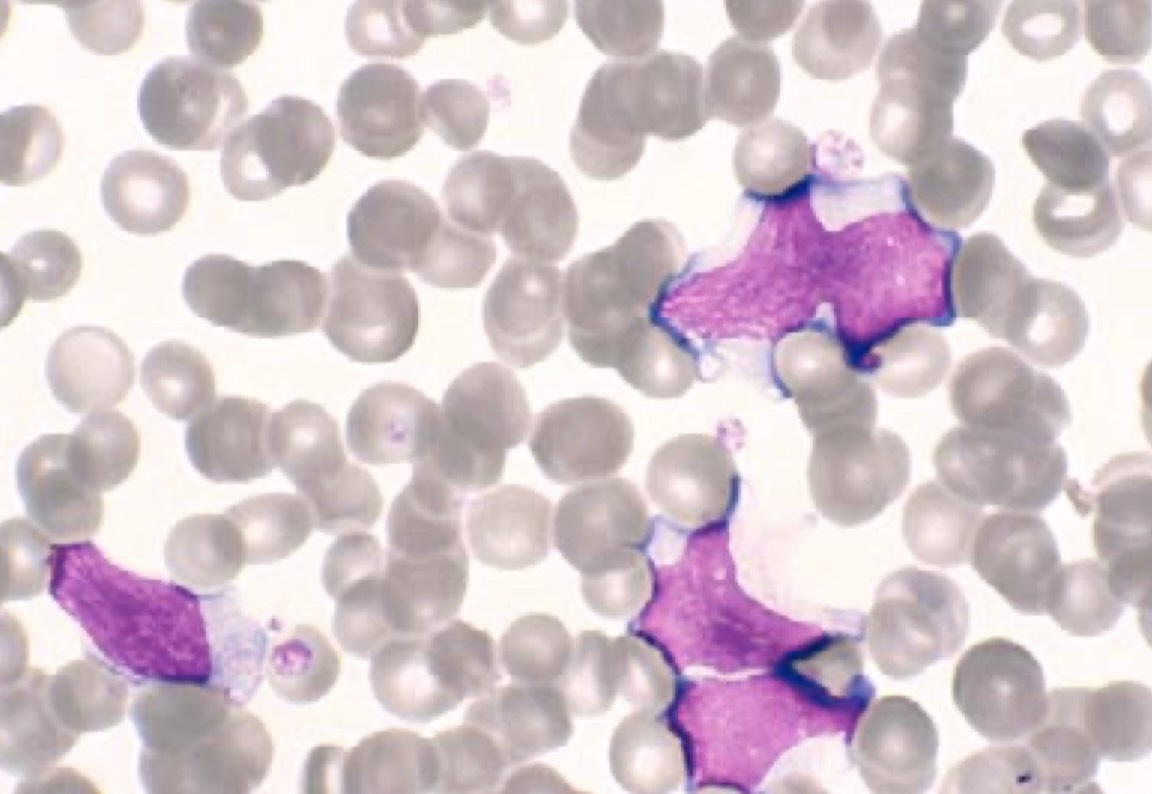
لنفوسیت آتیپیک در عفونت ویروسی

لنفوسیت آتیپیک چیست؟ بررسی کامل لنفوسیت آتیپیک (Atypical / Reactive Lymphocyte)
لنفوسیت آتیپیک چیست؟ لنفوسیت آتیپیک یا لنفوسیت واکنشی(لنفوسیت ری اکتیو)، لنفوسیتی است که در پاسخ به تحریک شدید سیستم ایمنی (معمولاً عفونتهای ویروسی مانند EBV و CMV) دچار بزرگشدن، پررنگ شدن سیتوپلاسم و تغییر شکل هسته میشود. لنفوسیت آتیپیک معمولاً نشانه فعال شدن سیستم ایمنی است و لزوماً به معنی سرطان خون یا لنفوم نیست، ولی در صورت ماندگاری طولانی یا همراهی با علائم هشدار باید دقیقتر بررسی شود.
جهت عضویت در کانال آموزشی هماتولوژی در تلگرام به لینک زیر مراجعه کنید:
https://t.me/hematology_education
فهرست مطالب لنفوسیت آتیپیک چیست
۱) تعریف لنفوسیت آتیپیک چیست؟
۲) فیزیولوژی و مکانیزم ایجاد لنفوسیت آتیپیک چیست؟
۳) مورفولوژی لنفوسیت آتیپیک در اسمیر خون محیطی
۴) انواع لنفوسیت آتیپیک (Downey types)
۵) علل و بیماریهای مرتبط با لنفوسیت آتیپیک چیست؟
۶) افتراق لنفوسیت آتیپیک از بلاستها و سلولهای بدخیم
۷) فلوسایتومتری لنفوسیت آتیپیک و مارکرهای CD
۸) نکات سیتوشیمی (Cytochemistry) در لنفوسیتهای آتیپیک
۹) الگوهای بالینی لنفوسیت آتیپیک در بیماریهای مختلف
۱۰) الگوریتم تشخیصی لنفوسیت آتیپیک در آزمایشگاه
۱۱) خطاهای رایج در تشخیص لنفوسیت آتیپیک
۱۲) لنفوسیت آتیپیک در کودکان، بزرگسالان و سالمندان
۱۳) درمان لنفوسیت آتیپیک چیست؟
۱۴) جمعبندی نهایی درباره لنفوسیت آتیپیک
سوالات رایج درباره لنفوسیت آتیپیک چیست
منابع برای مطالعه بیشتر در مورد لنفوسیت آتیپیک
۱) تعریف لنفوسیت آتیپیک چیست؟
لنفوسیت آتیپیک چیست؟ لنفوسیت آتیپیک (Atypical / Reactive Lymphocyte) به هر لنفوسیتی گفته میشود که تحت
تأثیر تحریک آنتیژنی شدید، دچار تغییرات قابلتوجه مورفولوژیک، متابولیک و ایمونولوژیک میشود. این سلولها نتیجه فعالشدن
سیستم ایمنی در برابر آنتیژنها، بهویژه عفونتهای ویروسی مانند EBV و CMV هستند و معمولاً نشاندهنده پاسخ ایمنی شدید هستند، نه لزوماً یک بدخیمی خون.
در لنفوسیت آتیپیک، ما شاهد افزایش اندازه سلول، افزایش RNA ریبوزومی (که باعث بازوفیلی سیتوپلاسم میشود)، تغییر در ساختار کروماتین هسته، و تقویت تماس سلول با سایر سلولها هستیم. به همین دلیل در اسمیر خون محیطی، این سلولها بهشدت از لنفوسیتهای کوچک نرمال متمایز هستند. این لنفوسیتهای واکنشی، در تمام شرایطی که سیستم ایمنی درگیر پاسخ شدید است دیده میشوند؛ از مونونوکلئوز عفونی گرفته تا عفونتهای ویروسی عمومی، واکنشهای دارویی شدید و برخی بیماریهای خودایمنی.
نکته مهم:
وجود لنفوسیت آتیپیک در CBC بهتنهایی به معنی سرطان خون یا لنفوم نیست. در اکثر موارد، لنفوسیت آتیپیک فقط نشاندهنده یک پاسخ ایمنی فعال است. تفسیر صحیح آن حتماً باید همراه با علائم بالینی، سایر پارامترهای CBC و بررسی اسمیر خون انجام شود.
اگر میخواهید با آزمایشهای پایهای خون محیطی و مغز استخوان که در کنار بررسی لنفوسیت آتیپیک درخواست میشوند بیشتر آشنا شوید، پیشنهاد میکنم مقاله
دوره جامع آموزش تصویری هماتولوژی فصل پنج: آزمایش های پایهای خون و مغز استخوان
را مطالعه کنید.
۲) فیزیولوژی و مکانیزم ایجاد لنفوسیت آتیپیک چیست؟
از دیدگاه هماتولوژی و ایمونولوژی، برای درک اینکه لنفوسیت آتیپیک چیست باید بدانیم که این سلولها چگونه از یک لنفوسیت کوچک و نرمال به یک لنفوسیت واکنشی بزرگ و فعال تبدیل میشوند. این فرآیند نتیجه فعالشدن لنفوسیتهای T و B در پاسخ به آنتیژن است.
۲.۱) آغاز فعالسازی T–Cell و تشکیل لنفوسیت آتیپیک
در اکثر موارد، بهویژه در عفونتهای ویروسی مثل EBV و CMV، لنفوسیتهای آتیپیک از نوع T-cell هستند که در پاسخ به آنتیژن
فعال شدهاند. مراحل فعالسازی شامل:
- ارائه آنتیژن توسط سلولهای ارائهدهنده آنتیژن (APC) مانند ماکروفاژ و دندریتیک سل
- اتصال آنتیژن به کمپلکس MHC-I یا MHC-II و شناسایی توسط TCR همراه با CD3
- فعال شدن مسیرهای سیگنالی داخل سلولی مانند NF-κB، MAPK، NFAT و افزایش Ca2+ داخل سلول
- بیان ژن IL-2 و گیرنده آن (CD25) و ورود لنفوسیت به فاز blast transformation
- افزایش حجم سلول، توسعه شبکه آندوپلاسمی خشن (RER) و دستگاه گلژی و افزایش سنتز پروتئین
- خروج سلولهای فعالشده از غدد لنفاوی و ورود آنها به خون محیطی به شکل لنفوسیتهای آتیپیک
۲.۲) نقش سیتوکینها در تشکیل لنفوسیت آتیپیک
مجموعهای از سیتوکینها در شکلگیری لنفوسیتهای آتیپیک نقش دارند و باعث ایجاد همان تصویر کلاسیک لنفوسیت واکنشی میشوند:
- IL-2: تحریک تکثیر و blast transformation لنفوسیتها
- IFN-γ: فعالسازی ماکروفاژها و افزایش سنتز پروتئین و RNA در لنفوسیت
- TNF-α: تشدید التهاب و افزایش چسبندگی و تماس سلولی (cell–cell interaction)
- IL-6: افزایش بازوفیلی سیتوپلاسم و بزرگشدن بیشتر لنفوسیت آتیپیک
نکته مهم ایمونولوژیک:
لنفوسیت آتیپیک در واقع نمای مورفولوژیک یک لنفوسیت فعالشده است؛ بنابراین در تفسیر لنفوسیت آتیپیک باید همواره آن را بهعنوان نشانهای از فعالیت ایمنی و نه الزاماً نشانهای از بدخیمی در نظر گرفت، مگر اینکه شواهد دیگری
به نفع بدخیمی وجود داشته باشد.
۳) مورفولوژی لنفوسیت آتیپیک در اسمیر خون محیطی
یکی از مهمترین بخشهای پاسخ به سؤال لنفوسیت آتیپیک چیست، شناخت ویژگیهای مورفولوژیک آن در اسمیر خون
محیطی است. بررسی دقیق پایدن اسمیر رنگآمیزی شده با رایت-گیمسا برای تشخیص لنفوسیت آتیپیک ضروری است.
لنفوسیت آتیپیک معمولاً بهصورت سلولهای بزرگ، با سیتوپلاسم فراوان و بازوفیل و هستهای نامنظم دیده میشود که از
لنفوسیتهای کوچک، هایپرکروماتیک و گردِ نرمال، کاملاً قابل افتراق است.
۳.۱) اندازه لنفوسیت آتیپیک
اندازه لنفوسیت آتیپیک معمولاً ۲ تا ۳ برابر لنفوسیت نرمال است. در حالی که لنفوسیتهای کوچک طبیعی حدود
۷–۱۰ میکرون هستند، لنفوسیت آتیپیک میتواند بین ۱۴ تا ۳۰ میکرون و حتی بزرگتر از مونوسیت باشد.
۳.۲) سیتوپلاسم لنفوسیت آتیپیک
سیتوپلاسم در لنفوسیت آتیپیک یک ویژگی کلیدی است و در پاسخ به اینکه لنفوسیت آتیپیک چیست، کمک زیادی میکند:
- Deep basophilic: سیتوپلاسم آبی پررنگ بهدلیل افزایش RNA ریبوزومی
- حاشیه نامنظم (scalloped border): مرز سیتوپلاسم ناهموار است.
- پدیده Skirting: سیتوپلاسم بین گلبولهای قرمز فرو میرود و آنها را در بر میگیرد.
- Granules آزوروفیل: در برخی عفونتها ممکن است دانههای ریز آزوروفیل دیده شوند.
- منطقه گلژی (Golgi zone) برجسته: به شکل ناحیه کمرنگ نزدیک هسته دیده میشود.
۳.3) هسته لنفوسیت آتیپیک
شکل هسته در لنفوسیت آتیپیک معمولاً:
- بیضی، لوبدار یا kidney-shaped
- دارای کروماتینی که در محیط متراکمتر و در مرکز کمی شلتر است (fingerprint pattern)
- نوکلئول ممکن است در برخی انواع (بهخصوص نوع Downey III) واضحتر باشد.
۳.۴) نسبت هسته به سیتوپلاسم (N:C ratio)
در لنفوسیت آتیپیک، نسبت هسته به سیتوپلاسم نسبت به بلاستهای لوسمیک کمتر است، زیرا سیتوپلاسم فراوانتر است. این موضوع در افتراق لنفوسیت آتیپیک از بلاستها بسیار کمککننده است.
نکته بسیار مهم مورفولوژیک:
hallmark لنفوسیت آتیپیک، سیتوپلاسم بازوفیل فراوان با مرز نامنظم و پدیده skirting است. در مقابل،
بلاستها سیتوپلاسم کم، N:C بالا و کروماتین بسیار شل با نوکلئولهای واضح دارند.
برای مشاهده بهتر این تفاوتها، استفاده از رنگآمیزی استاندارد بسیار مهم است. پیشنهاد میکنم مقاله
روش رنگ آمیزی رایت گیمسا (Wright-Giemsa Staining Method): آموزش کامل مراحل، نکات و کنترل کیفی
را مطالعه کنید تا دید دقیقتری نسبت به مورفولوژی لنفوسیت آتیپیک در اسمیر خون پیدا کنید. در ادامه میتوانید مورفولوژی های مختلف لنفوسیت آتیپیک یا لفوسیت ری اکتیو را مشاهده کنید:

لنفوسیت ری اکتیو در مونونوکلئوز عفونی
لنفوسیت های ری اکتیو در مونونوکلئوز عفونی
لنفوسیت آتیپیک در عفونت سایتومگالو ویروس

لنفوسیت های ری اکتیو در مونونوکلئوز عفونی
۴) انواع لنفوسیت آتیپیک (Downey Types)
در پاسخ به این سؤال که لنفوسیت آتیپیک چیست، باید به این نکته هم توجه کرد که این سلولها خود شامل انواع مختلفی هستند که بهخصوص در مونونوکلئوز عفونی (EBV) بهصورت کلاسیک توصیف شدهاند. این انواع در منابع هماتولوژی با نام
Downey cells شناخته میشوند.
۴.۱) Downey Type I (Plasmacytoid)
در این نوع از لنفوسیت آتیپیک:
- سلول ظاهری شبیه پلاسمابلاست دارد.
- هسته معمولاً اکسنتریک (کناری) است.
- سیتوپلاسم deeply basophilic است.
- در مراحل اولیه مونونوکلئوز عفونی دیده میشود.
۴.۲) Downey Type II (کلاسیکترین نوع لنفوسیت آتیپیک)
این نوع شایعترین و کلاسیکترین تصویر لنفوسیت آتیپیک است و بیشترین ارتباط را با سؤال لنفوسیت آتیپیک چیست در ذهن
متخصصان دارد:
- سلول بزرگ با سیتوپلاسم وسیع و بازوفیل
- حاشیه سیتوپلاسم نامنظم و interdigitated با RBC ها (ballerina skirt)
- در مونونوکلئوز عفونی EBV تقریباً hallmark است.
۴.۳) Downey Type III (Immunoblast-like)
در این نوع:
- سلول بسیار بزرگ (تا ۳۰–۳۵ میکرون)
- نوکلئول prominent و واضح
- شباهت زیاد به لنفوبلاستهای لوسمیک و امکان اشتباه در تشخیص
نکته مهم آموزشی برای هماتولوژیستها:
Downey Type III از نظر ظاهری میتواند با لنفوبلاست اشتباه گرفته شود. در اینجا توجه به کروماتین، زمینه بالینی، الگوی
فلوسایتومتری و سایر پارامترهای CBC بسیار اهمیت دارد.
۵) علل و بیماریهای مرتبط با لنفوسیت آتیپیک چیست؟
یکی از مهمترین بخشهای پاسخ به سؤال لنفوسیت آتیپیک چیست، شناخت علتها و بیماریهایی است که باعث
ایجاد این سلولهای واکنشی میشوند. بیشترین اهمیت با عفونتهای ویروسی است، اما عفونتهای باکتریال، انگلی، واکنشهای دارویی و بیماریهای خودایمنی نیز میتوانند لنفوسیت آتیپیک ایجاد کنند.
۵.۱) EBV و CMV – الگوی کلاسیک لنفوسیت آتیپیک
در عفونت EBV (عامل مونونوکلئوز عفونی)، ویروس مستقیماً سلولهای B را آلوده میکند؛ اما لنفوسیت آتیپیک
که در خون محیطی میبینیم عمدتاً T-cell واکنشی است که علیه این B-cell های آلوده فعال شده است. نتیجه این پاسخ ایمنی، حضور گسترده Downey Type II در اسمیر خون است. در عفونت CMV نیز لنفوسیتهای آتیپیک بزرگ و گاهی با سیتوپلاسم foamy دیده میشوند. الگو کمی با EBV متفاوت است، اما از نظر مورفولوژیک، هر دو در گروه لنفوسیتهای واکنشی قرار میگیرند.
۵.۲) COVID-19 و لنفوسیتهای plasmacytoid
در بیماران COVID-19، علاوه بر لنفوسیتوپنی، گاهی لنفوسیتهای آتیپیک plasmacytoid با هسته اکسنتریک و سیتوپلاسم بازوفیل مشاهده میشوند. این الگو نوعی «واکنش ایمنی شدید» است که در برخی بیماران دیده میشود.
۵.۳) توکسوپلاسموز و سایر عفونتهای انگلی
در توکسوپلاسموز، لنفوسیت آتیپیک معمولاً کمی کوچکتر از EBV و با بازوفیلی کمتر است، اما همچنان نمای واکنشی دارد. در
مالاریا، لیشمانیوز و سایر عفونتهای مزمن نیز میتوان لنفوسیتهای آتیپیک را مشاهده کرد.
۵.۴) واکنش دارویی (DRESS Syndrome)
DRESS (Drug Rash with Eosinophilia and Systemic Symptoms) یک سندرم شدید واکنشی به دارو است که با تب، راش پوستی، ائوزینوفیلی، افزایش آنزیمهای کبدی و حضور لنفوسیتهای آتیپیک همراه است. داروهای شایع در ایجاد DRESS:
- Phenytoin
- Carbamazepine
- Sulfonamides
- Allopurinol
- Vancomycin
نکته مهم بالینی:
در واکنشهای دارویی شدید، حضور لنفوسیت آتیپیک همراه با ائوزینوفیلی و افزایش شدید آنزیمهای کبدی، زنگ خطر DRESS
syndrome است و نیاز به مداخله سریع و قطع داروی مسئول دارد.
۶) افتراق لنفوسیت آتیپیک از بلاستها و سلولهای بدخیم
از مهمترین جنبههای پاسخ به سؤال لنفوسیت آتیپیک چیست، این است که بدانیم چگونه آن را از بلاستهای
لوسمیک و سایر سلولهای بدخیم افتراق دهیم. در اینجا مقایسه جزئی و فوقتخصصی ارائه میشود.
| ویژگی | لنفوسیت آتیپیک (Reactive) | Leukemic blast | سلول لنفومی |
|---|---|---|---|
| کروماتین | نسبتاً متراکم (moderately clumped) | کاملاً شل و open | متغیر اما اغلب coarse |
| نوکلئول | کمرنگ، باریک یا نامشخص | واضح و بزرگ | متغیر |
| سیتوپلاسم | فراوان و بازوفیل | کم و کمرنگ | متوسط |
| Skirting | hallmark (وجود دارد) | وجود ندارد | وجود ندارد |
| N:C ratio | کمتر از بلاست | بسیار بالا | متغیر |
| کلونالیته | پلیکلونال | مونوکلونال | مونوکلونال |
نکته کلیدی در افتراق لنفوسیت آتیپیک از بلاست:
در بلاستها کروماتین بسیار شل، سیتوپلاسم کم، N:C بالا و نوکلئولهای واضح و متعدد دیده میشود. در مقابل، لنفوسیت
آتیپیک سیتوپلاسم فراوان و بازوفیل، skirting و کروماتین نسبتاً متراکم دارد. در موارد مشکوک، فلوسایتومتری و بررسی
ایمنوفنوتیپ ضروری است.
۷) فلوسایتومتری لنفوسیت آتیپیک و مارکرهای CD
برای پاسخ دقیقتر به اینکه لنفوسیت آتیپیک چیست، لازم است از دیدگاه فلوسایتومتری و مارکرهای CD نیز
به موضوع نگاه کنیم. افتراق بین لنفوسیت آتیپیک (واکنشی) و لنفوسیت نئوپلاستیک (بدخیم) بر پایه الگوی ایمنوفنوتیپی انجام
میشود.
۷.۱) ایمنوفنوتیپ لنفوسیت آتیپیک (Reactive)
- افزایش CD3+ T-cells
- افزایش بیشتر CD8 نسبت به CD4 (کاهش CD4/CD8 ratio)
- افزایش بیان HLA-DR
- Ki-67 در حد low تا moderate
- نسبت زنجیرههای سبک Kappa/Lambda طبیعی (پلیکلونال)
- CD45 معمولاً bright
۷.۲) ایمنوفنوتیپ لنفوسیت نئوپلاستیک
- CD45 ممکن است dim یا variable باشد.
- skewing در نسبت Kappa/Lambda (مونوکلونالیتی)
- CD10 و TdT مثبت در ALL
- CD5 و CD23 مثبت در CLL
- CD30 مثبت در برخی لنفومها (مثل Hodgkin)
- Ki-67 معمولاً بسیار بالا در بدخیمیها
اگر در گزارش CBC و اسمیر خون، شک به بدخیمی وجود داشته باشد، فلوسایتومتری یکی از اجزای مهم الگوریتم تشخیصی شما است و مکمل ارزیابی مورفولوژیک لنفوسیت آتیپیک خواهد بود.
۸) نکات سیتوشیمی (Cytochemistry) در بررسی لنفوسیت آتیپیک
در برخی مراکز، برای افتراق بهتر لنفوسیت آتیپیک از بلاستها، از رنگآمیزیهای سیتوشیمی استفاده میشود. اگرچه امروزه
فلوسایتومتری نقش پررنگتری دارد، اما دانستن الگوی سیتوشیمی درک بهتری از اینکه لنفوسیت آتیپیک چیست
به ما میدهد.
- PAS: معمولاً منفی یا بهصورت patchy ضعیف مثبت؛ در حالی که در برخی بلاستها بلوکهای PAS-positive دیده میشود.
- Sudan Black: در لنفوسیت آتیپیک منفی است.
- MPO: منفی؛ در مقابل بلاستهای میلوئیدی MPO مثبت هستند.
- Non-specific esterase: ممکن است در برخی موارد واکنش ضعیف مثبت نشان دهد.
۹) الگوهای بالینی لنفوسیت آتیپیک در بیماریهای مختلف
برای درک بهتر اینکه لنفوسیت آتیپیک چیست و در چه شرایطی اهمیت بیشتری دارد، باید الگوی حضور آن را در بیماریهای مختلف بشناسیم.
۹.۱) EBV (مونونوکلئوز عفونی)
- WBC↑
- Lymphocytosis marked
- لنفوسیت آتیپیک: ۲۰–۵۰٪
- افزایش آنزیمهای کبدی (LFT↑)
- اسپلنومگالی و لنفادنوی
۹.۲) CMV
- لنفوسیت آتیپیک بزرگتر از EBV
- بیمار ممکن است بدون فارنژیت و لنفادنوی شدید باشد.
۹.۳) هپاتیتهای ویروسی (A, B, C)
- لنفوسیتهای آتیپیک بهویژه در فاز prodromal
- افزایش چشمگیر آنزیمهای کبدی
۹.۴) HIV (فاز حاد)
- حضور گذرای لنفوسیتهای آتیپیک
- تب، راش، علائم شبیه مونونوکلئوز
۹.۵) COVID-19
- لنفوسیتوپنی شایع است.
- اما در برخی بیماران، لنفوسیتهای آتیپیک plasmacytoid دیده میشود.
۹.۶) DRESS Syndrome
- ائوزینوفیلی شدید
- لنفوسیت آتیپیک
- افزایش بسیار زیاد ALT/AST
- راش پوستی و تب
برای کنترل کیفی نتایج CBC و بررسی صحیح اسمیر خون در شرایطی که لنفوسیت آتیپیک دیده میشود، مطالعه مقاله
کنترل کیفی هماتولوژی
میتواند برای متخصصان آزمایشگاه بسیار مفید باشد.
۱۰) الگوریتم تشخیصی لنفوسیت آتیپیک در آزمایشگاه
برای اینکه بدانیم در عمل با مشاهده لنفوسیت آتیپیک در CBC چه کنیم، باید یک الگوریتم تشخیصی گامبهگام
داشته باشیم. این الگوریتم به متخصصان علوم آزمایشگاهی کمک میکند تا گزارش دقیقتری ارائه دهند.
۱۰.۱) Step 1 – بررسی CBC
- WBC بالا یا پایین؟
- آیا Lymphocytosis وجود دارد؟
- همراهی با آنمی یا ترومبوسیتوپنی؟
۱۰.۲) Step 2 – بررسی اسمیر خون محیطی
- وجود لنفوسیتهای آتیپیک با مورفولوژی واکنشی؟
- آیا بلاست یا سلولهای مشکوک بدخیمی دیده میشود؟
- وجود Downey type II یا III؟
۱۰.۳) Step 3 – ارتباط با علائم بالینی
- تب، گلودرد، لنفادنوی، اسپلنومگالی → احتمال EBV/CMV
- راش پوستی، داروی جدید، ائوزینوفیلی → احتمال DRESS
- یافتههای کبدی و زردی → احتمال هپاتیت
۱۰.۴) Step 4 – تستهای تکمیلی آزمایشگاهی
- EBV panel (VCA IgM/IgG, EBNA)
- CMV IgM
- HIV Ag/Ab
- Hepatitis panel
- Toxo IgM (خصوصاً در بارداری)
- COVID PCR در صورت شک بالینی
۱۰.۵) Step 5 – فلوسایتومتری و Bone Marrow در موارد مشکوک
- لنفوسیت بالای ۵۰ هزار
- لنفادنوی یا اسپلنومگالی پایدار بیش از ۲ ماه
- کاهش وزن، تعریق شبانه، تب طولانی
- همراهی با پانسیتوپنی
برای تسلط بیشتر بر الگوریتمهای تشخیصی در هماتولوژی و ارتباط بین آزمایشهای پایهای و تفسیر اسمیر خون، مطالعه مقاله
دوره جامع آموزش تصویری هماتولوژی فصل پنج: آزمایش های پایهای خون و مغز استخوان
توصیه میشود.
۱۱) خطاهای رایج در تشخیص لنفوسیت آتیپیک
شناخت خطاهای رایج در تشخیص لنفوسیت آتیپیک، بخش مهمی از پاسخ به سؤال لنفوسیت آتیپیک چیست در عمل آزمایشگاهی است.
- اشتباه گرفتن Downey Type III با لنفوبلاستهای لوسمیک
- اشتباه گرفتن Smudge cell در CLL با لنفوسیت آتیپیک (در حالیکه Smudge cell بقایای تخریبشده لنفوسیت است)
- نادیده گرفتن لنفوسیتهای واکنشی در عفونتهای ویروسی خفیف
- اشتباه در طبقهبندی توسط دستگاههای Auto-analyzer بدون بررسی اسمیر
- اشتباه گرفتن lymphoplasmacytoid reactive cell در COVID-19 با plasma cell بدخیم
۱۲) لنفوسیت آتیپیک در کودکان، بزرگسالان و سالمندان
معنای بالینی لنفوسیت آتیپیک چیست؟ پاسخ تا حد زیادی به سن بیمار وابسته است و در کودکان، بزرگسالان و سالمندان تفاوت
دارد.
۱۲.۱) کودکان
- وجود لنفوسیت آتیپیک در کودکان بسیار شایع است.
- بیشتر ناشی از عفونتهای ویروسی تنفسی و EBV است.
- اغلب موارد خوشخیم و خودمحدود شوندهاند.
۱۲.۲) بزرگسالان
- شایعترین علل: EBV، CMV، هپاتیتها، واکنش دارویی
- نیاز به ارتباط دقیق با علائم بالینی
۱۲.۳) سالمندان
- هرگونه Lymphocytosis همراه با لنفوسیت آتیپیک در سالمندان باید با دقت بررسی شود.
- بررسی CLL و سایر لنفومها با فلوسایتومتری ضروری است.
۱۳) درمان لنفوسیت آتیپیک چیست؟
درمان مستقیم برای «لنفوسیت آتیپیک» وجود ندارد، چون این سلولها خودِ بیماری نیستند بلکه بازتاب پاسخ ایمنی
به یک علت زمینهای هستند. بنابراین در پاسخ به سؤال درمان لنفوسیت آتیپیک چیست، باید گفت: درمان، همان درمان علت زمینهای است.
- در عفونتهای ویروسی ساده → درمان حمایتی، استراحت، مایعات، کنترل تب
- در عفونتهای باکتریایی → آنتیبیوتیک مناسب
- در بیماریهای خودایمنی → کورتیکواستروئید و سایر داروهای ایمونوساپرسیو
- در DRESS syndrome → قطع فوری داروی مسئول + کورتون
- در بدخیمیها → درمان اختصاصی هماتولوژی (شیمیدرمانی، ایمونوتراپی و…)
۱۴) جمعبندی نهایی درباره لنفوسیت آتیپیک چیست؟
در پایان، میتوان پاسخ سؤال لنفوسیت آتیپیک چیست را در چند نکته کلیدی خلاصه کرد:
- لنفوسیت آتیپیک نمای مورفولوژیک یک لنفوسیت فعالشده است، نه الزاماً یک سلول بدخیم.
- شایعترین علت حضور لنفوسیت آتیپیک، عفونتهای ویروسی مانند EBV و CMV است.
- مورفولوژی (ویژه skirting و بازوفیلی سیتوپلاسم) کلید تشخیص است.
- Downey Type II کلاسیکترین تصویر لنفوسیت آتیپیک در مونونوکلئوز عفونی است.
- فلوسایتومتری ابزار اصلی افتراق لنفوسیت آتیپیک واکنشی از لنفوسیت نئوپلاستیک است.
- در کودکان، اغلب خوشخیم و گذرا؛ در سالمندان، نیازمند بررسی یا رول اوت کردن CLL و لنفوم است.
- درمان لنفوسیت آتیپیک، همان درمان علت زمینهای است و خود سلول هدف درمان مستقیم نیست.
سوالات رایج درباره لنفوسیت آتیپیک چیست؟
۱. لنفوسیت آتیپیک چیست و چه فرقی با لنفوسیت معمولی دارد؟
لنفوسیت آتیپیک یک لنفوسیت فعالشده است که در پاسخ به تحریک آنتیژنی (مثلاً عفونت ویروسی) بزرگتر، بازوفیلتر و با هسته نامنظمتر از لنفوسیت معمولی دیده میشود. این سلولها نشانه فعال شدن سیستم ایمنی هستند، نه الزاماً سرطان خون.
۲. وجود لنفوسیت آتیپیک در CBC به چه معناست؟
وجود لنفوسیت آتیپیک در CBC معمولاً نشاندهنده یک عفونت ویروسی (مثل EBV، CMV، هپاتیتها) یا واکنش ایمنی شدید است. تفسیر آن باید همراه با علائم بالینی، سایر پارامترهای CBC و بررسی اسمیر خون توسط کارشناس هماتولوژی انجام شود.
۳. چه درصدی از لنفوسیت آتیپیک نگرانکننده است؟
بهطور کلی، مقادیر کمتر از ۵٪ معمولاً اهمیت چندانی ندارند. مقادیر ۱۰–۲۰٪ اغلب در مونونوکلئوز عفونی و عفونتهای ویروسی
شدید دیده میشود و بالاتر از ۲۰–۳۰٪ نیازمند بررسی دقیقتر است؛ بهخصوص اگر با علائم شدید یا یافتههای غیرطبیعی دیگر همراه باشد.
۴. لنفوسیت آتیپیک در کودکان خطرناک است؟
در کودکان، لنفوسیت آتیپیک بسیار شایع و اغلب ناشی از عفونتهای ویروسی ساده است. در اکثر موارد خوشخیم و خودمحدود
شونده است؛ اما اگر با تب طولانی، کاهش وزن، ضعف شدید یا بزرگشدن قابل توجه غدد لنفاوی همراه باشد، باید جدیتر بررسی شود.
۵. لنفوسیت آتیپیک در بارداری چه اهمیتی دارد؟
در بارداری، وجود لنفوسیت آتیپیک میتواند ناشی از عفونتهایی مانند CMV، EBV یا توکسوپلاسموز باشد که برخی از آنها برای
جنین مهم هستند. بنابراین در صورت مشاهده لنفوسیت آتیپیک در بارداری، ارزیابی کامل بالینی و آزمایشهای تکمیلی ضروری است.
۶. آیا لنفوسیت آتیپیک همیشه به معنی مونونوکلئوز عفونی است؟
خیر. اگرچه مونونوکلئوز عفونی (EBV) کلاسیکترین علت لنفوسیت آتیپیک است، اما CMV، هپاتیتها، HIV، COVID-19، توکسوپلاسموز، واکنشهای دارویی و حتی بیماریهای خودایمنی نیز میتوانند باعث ایجاد لنفوسیت آتیپیک شوند.
۷. آیا لنفوسیت آتیپیک خودبهخود از بین میرود؟
بله. در اکثر موارد، با برطرف شدن علت زمینهای (مثلاً عفونت ویروسی)، لنفوسیتهای آتیپیک بهتدریج کاهش یافته و شمارش
لنفوسیتها به حالت طبیعی برمیگردد. اگر این وضعیت طولانیمدت باقی بماند، باید بهدنبال علل جدیتر گشت.
۸. برای تأیید لنفوسیت آتیپیک چه آزمایشهایی لازم است؟
ابتدا CBC و بررسی اسمیر خون با رنگآمیزی رایت-گیمسا انجام میشود. سپس با توجه به علائم بیمار، تستهایی مانند EBV panel، CMV IgM، HIV، Hepatitis panel، Toxo IgM و در صورت لزوم فلوسایتومتری و Bone marrow انجام میشود.
۹. آیا لنفوسیت آتیپیک میتواند نشانه سرطان خون باشد؟
خودِ لنفوسیت آتیپیک بهتنهایی نشانه سرطان خون نیست، اما اگر همراه با علائم هشدار (مثل کاهش وزن، تعریق شبانه، لنفادنوپاتی پایدار، پانسیتوپنی، WBC بسیار بالا) باشد، باید با فلوسایتومتری و سایر روشها بدخیمیها را رد کرد.
۱۰. چه زمانی باید برای وجود لنفوسیت آتیپیک به متخصص مراجعه کرد؟
اگر وجود لنفوسیت آتیپیک همراه با تب طولانی، ضعف شدید، کاهش وزن، تعریق شبانه، بزرگی غدد لنفاوی یا طحال، یا اختلال در
سایر پارامترهای CBC (مثل آنمی و ترومبوسیتوپنی) باشد، مراجعه به متخصص خون و آنکولوژی ضروری است.
منابع برای مطالعه بیشتر در مورد لنفوسیت آتیپیک
دوره جامع آموزش تصویری هماتولوژی فصل پنج: آزمایش های پایهای خون و مغز استخوان
روش رنگ آمیزی رایت گیمسا (Wright-Giemsa Staining Method): آموزش کامل مراحل، نکات و کنترل کیفی
کنترل کیفی هماتولوژی
American Society of Hematology (ASH)
- Wintrobe’s Clinical Hematology, 14th Edition
- Henry’s Clinical Diagnosis and Management by Laboratory Methods